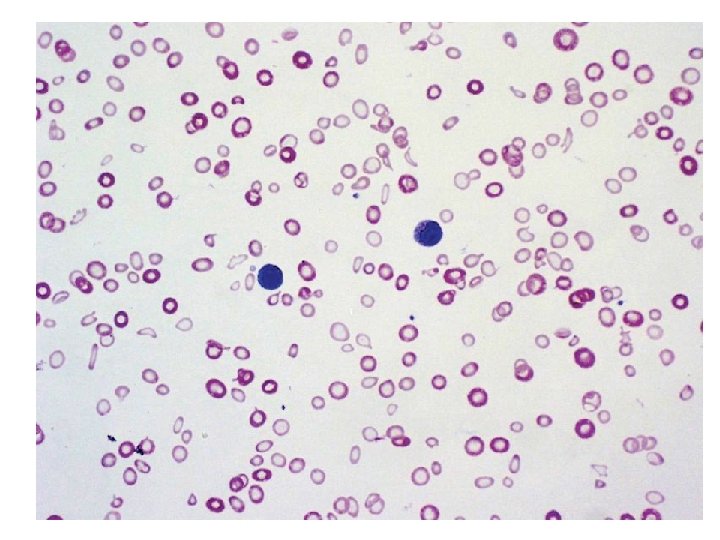

Board Review Anemia Greg Radin 792013 Anemia Definition

Board Review: Anemia Greg Radin 7/9/2013

Anemia • Definition: Insufficient erythrocytes to carry O 2 to peripheral tissues • Symptoms: Tachycardia, DOE, decreased exercise tol, pallor depend on severity and acuity • Low O 2 in kidney EPO release RBC production in bone marrow

Approach to Anemia • 3 mechanisms: – Blood loss – Hemolysis – Underproduction • Retic count will be low in underproduction, high in blood loss or hemolysis – Be careful w/ low retic count in the elderly

UNDERPRODUCTION ? elevated LDH, indirect bili ? Low haptoglobin HEMOLYSIS Review risk factors Review Smear…

Hemolytic anemia • Membrane defects – Hereditary spherocytosis • Enzyme deficiencies – G 6 PD deficiency • Hemoglobinopathy – Sickle cell • Immune hemolysis – Cold, warm, drug induced • Mechanical: – – Intravascular foreign body (ie mechanical valve) Repeated trauma (“march hemolysis”) Malaria/babesia microangiopathy

UNDERPRODUCTION ? elevated LDH, indirect bili ? Low haptoglobin HEMOLYSIS Review risk factors Review Smear… MCV Review Smear… Review risk factors?

Hypoproliferative anemias Bone marrow bx may be helpful

• 77 M presents with 1 year fatigue & DOE, 8 weeks substernal exertional CP • Vitals: T 36. 7 137/78 HR 118, RR 17 • Pale conjunctiva, summation gallop, bibasilar crackles • Hb 5. 4, MCV 58 RDW 25 • WBC 6. 4, Plt 154 • Smear… • • • Cause of anemia? A) G 6 PD deficiency B) Iron deficiency C) Myelofibrosis D) TTP

• Most likely diagnosis is iron deficiency. – – Ferritin <15 highest diagnostic accuracy High RDW May have thrombocytosis (benign) BM bx for stainable iron is gold standard (rarely necessary) • Smear: variations in erythrocyte size and shape (anisopoikilocytosis) and increased central pallor. • Pt’s may have symptoms of iron-deficiency without anemia – Fatigue, irritability, headache, pica • Treatment: PO iron salts – Take on an empty stomach (absorbtion inhibited by antacids, abx, cereals dietary fibers – Expect reticulocytosis in 7 -12 days, Hb increase in several weeks • Try stopping iron after 3 -6 months – only use IV if unable to absorb, failure of treatment, or on HD • Must look for source of blood loss (menstrual, colon CA)

• 22 F recently diagnosed with SLE manifesting as painful joints, malar photosensitive rash, oral aphthous ulcers, and a positive antinuclear antibody and anti-Smith abs. Normal menses • Meds: hydroxychloroquine and a multivitamin. • Vitals: 37. 2 °C (99. 0 °F), BP 126/78, HR 88/min, RR 17/min. BMI is 20. • malar rash and thinning hair, no joint abnormalities, oral lesions, pericardial or pleural rubs, or heart murmurs. • Hb 8. 2 WBC 3. 9 • Iron 18, TIBC 180, Ferritin 556 • Cr 1. 0 • Smear… • • • Cause of anemia? A) inflammatory anemia B) iron deficiency C) MAHA D) Warm ab-associated hemolysis


• The patient has inflammatory anemia. • Initially normocytic and normochromic but can become hypochromic and microcytic over time. • Reticulocyte count: low • Iron: low or normal TIBC: low Ferritin: high • Smear: normal or may show microcytic hypochromic erythrocytes as in iron deficiency, not diagnostic • Pathophysiology: elevated hepcidin levels that develop in response to inflammatory cytokines, including interleukin-1, interleukin-6, and interferon decreases iron absorption from the gut and the release of iron from macrophages • Treatment: treat underlying process

• • • 87 M seen for f/u of 8 months asymptomatic anemia PMH: HTN, HL Meds: lisinopril, atorvastatin, ASA 81 Vitals: T 98. 0 BP 137/78, HR 88, RR 17 BMI 19 Exam: +S 4, otherwise normal Hb 11. 4 WBC 6. 2, Plt 225 MCV 90, Retic 0. 8% Iron 78, TIBC 356 Ferritin 187 Creatinine 1. 5 Smear: normocytic, normochromic anemia • • • Most likely cause? A) old age B) inflammatory C) iron deficiency D) kidney disease

Anemia of kidney disease • Reduced EPO production due to renal cortical loss • Onset around GFR of 60 • Dx: rule out other causes of anemia – Consider measuring EPO level if uncertain • Tx: EPO-stimulating agent if needed after correction of other factors • Anemia is always pathologic even if elderly

• Primarily occurs in renal peritubular capillary endothelium • Liver takes over at a lower Hb setpoint in ESRD

• 29 F college student at PCP to establish care • Full-time college student, runs 3 miles twice weekly, but complains of mild fatigue in the evening. • PMH: hereditary sperocytosis (onset at age 10) • Meds: folate • Vitals: T 97. 4, BP 133/62, HR 68, RR 18 • Exam: scleral icterus, no adenopathy, normal heart/lungs. Spleen palpable below the costal margin • Hb: 11. 2 ( 11. 5 3 yrs ago) WBC 5. 9 Plt 172 • MCV 103, Retic 3. 4% • Abd US mild splenomegaly, no gallstones • • • Treatment? A) Cholecystectomy B) corticosteroids C) splenectomy D) supportive care


Hereditary spherocytosis • Pathophys: defect in structural RBCs proteins. Most common ankyrin, but also spectrin, band 3, band 4. 2 – RBCs trapped and destroyed by the spleen • DX: – Family hx (autosomal dominant, may be sporadic) – Osmotic fragility test: increased RBC fragility in hypotonic saline – Consider Coombs test—spherocytes seen in autoimmune hemolysis • • • Clinical course: varies from asymptomatic to severe anemia Complications: leg ulcers, pigmented gallstones If mild, no treatment necessary Splenectomy: curative Prophylactic cholecystectomy at time of splenectomy controversial in pts WITH gallstones

• • • 87 F with CC: 6 months numbness and tingling in her feet Eats a normal diet, no ETOH T normal, BP 127/85 HR 98 RR 28 BMI 20 Exam: pale conjunctivae, +icterus, decreased vibratory sensation in her toes. Finger and toenails normal. Hb: 6. 9 WBC 3. 9 Plt 49 T bili 4. 9 LDH 520 MMA elevated, HC elevated Vitamin B 12: 224 Smear… • • • Treatment? A) oral B 12 B) oral folate C) parenteral B 12 D) parenteral folate • •


B 12 deficiency • Dx: elevated HC, MMA (B 12 level may be normal) – Contrast with folate def. , only HC elevated, no neurotoxicity • Elevated LDH and indirect hyperbili due to ineffective erythropoesis, intravascular hemolysis • Testing for etiology no longer important as tx the same. • Smear: macrocytosis, hypersegmented neutrophils (>5 lobes) • Lack of vibratory sense and paresthesia weakness, spasticity, paraplegia • Most common cause: malabsorbtion • Treatment: high dose PO B 12 (1000 -2000 mcg daily), equivalent to parenteral

• 17 F here for f/u of microcytic anemia identified on routine CBC 3 weeks ago • Otherwise healthy, no significant PMH or FH • Med: OCP • Vitals: BP 117/78 HR 88 RR 17 BMI 19 • Exam: Conjunctival pallor, otherwise normal • Hb 11. 6 WBC 5. 4 Plt 213 • MCV 60, RDW 15, RBC count 5. 5 x 10^6 • Retic Count: 2. 3% • • • Dx? A) hereditary spherocytosis B) iron deficiency C) sideroblastic anemia D) B-thalassemia trait

Thalassemias • Due to abnormalities in the globin-producing genes. • May be difficult to distinguish from iron-deficiency, also consider lead poisoning • RBC indices: microcytic anemia, normal or increased RBC count. • Mentzer index: MCV/RBC count. If <13, usually assoc w/ B-thal (our pt = 11) • Target cells, microcytosis, hypochromia. • Hemoglobin electrophoresis: – Beta: decreased Hb. A, increased Hb A 2 and F – Alpha: normal in adults (no alternative a-globin) • Severity of anemia depends on amt of synthesis of affected globin gene. • Tx: transfusions as needed, iron chelation, HSCT

• • • 25 15 M seen in ED for subacute fatigue, SOB, lethargy. 2 weeks fever, arthralgia which improved this week. Sick contact: cousin PMH: Hb SS (infrequent pain crises, no CVA or acute chest). Immunizations UTD Meds: folate 2 mg/d VS: T 96. 4, BP 96/55, HR 114, RR 22 Exam: pale, lethargic No rash, normal heart and lungs, no adenopathy or splenomegaly CXR normal

• • • Diagnosis? A) aplastic crisis B) hyperhemolytic crisis C) megaloblastic crisis D) splenic sequestration crisis

Causes of acute worsening of chronic anemia • Aplastic crisis: Usually due to Parvovirus B 19, which supresses RBC production. – can confirm dx by anti-parvovirus Ig. M or PCR for parvo – Low retic count • Hyperhemolytic crisis: high retic count (rare) • Megaloblastic crisis: folate deficiency in pts with high RBC turnover (pregnancy, rapid growth, hemolytic anemia) • Splenic sequestration crisis: splenic vasoocclusion and pooling of blood. – Rapid drop in Hb, high retic count – Rapidly enlarging spleen, LUQ pain

• 55 M presents w/ 2 months L chest pain, SOB, diffuse joint pain, hematuria, LE swelling • Healthy, lifts weights and jogs 3 x weekly • PMH: sickle cell trait, HTN, HL • Meds: HCTZ, simva • VS: normal, Exam normal • Hb 14. 2, WBC 8. 6 Plt 239 • MCV 85, Retic 1. 9% • Hb electrophoresis Hb A 59%, Hb S 39% Hb F 2% • Smear, ECG, CXR all normal • • • Which symptoms can be attributed to sickle cell trait? A) hematuria B) CP C) diffuse joint pain D) leg swelling E) shortness of breath

Sickle cell trait • Benign condition with normal CBC • Complications: hematuria (common, probably due to renal papillary necrosis), renal medullary CA, VTE, splenic rupture • Seek alternative explanations for other symptoms in sickle cell trait

• 32 M with fatigue, dyspnea, lethargy, yellow eyes x 1 week • PMH: MRSA cellulitis successfully treated with 14 days TMP/SMX completed yesterday. • VS: T 98. 4, BP 103/53, HR 112, RR 16 • Exam: scleral icterus, tachycardia, otherwise normal • Hb 9. 6, WBC 8. 9 Plt 259 • MCV 104 ( 85 3 years ago), retic 6. 4% • Smear… • • • Diagnosis? A) cold agglutinin disease B) G 6 PD deficiency C) hereditary spherocytosis D) sickle cell disease E) thalassemia


G 6 PD deficiency • Acute hemolytic episode after oxidant drug such as bactrim (dapsone, primaquine, nitrofurantoin) • Smear shows bite cells • Heinz body: denatured oxidized hemoglobin (special stain) • Tx: withdraw offending agent • Board trickery: Don’t check G 6 PD level during acute crisis (increased retic fraction, retics have more of the enzyme) – Check in a few months

• • • 43 M p/w 2 days severe abd pain. PMH: recent dx of pancytopenia FH: negative Med: multivitamin VS: 97. 2, BP 143/69, HR 86, RR 12 Exam: jaundice, no splenomegaly, otherwise normal Hb 10. 4, WBC 3. 4, Plt 89 Haptoglobin: 0, LDH 775, T/D bili 2. 8/0. 4 Retic count 7% CBC and LFTs 1 year ago were normal CT A/P: mesenteric vein thrombosis, no adenopathy or splenomegaly. • • • Next diagnostic step? A) Direct coombs test B) Factor V Leiden assay C) Flow cytometry for CD 55 and CD 59 D) lupus anticoagulant and anti cardiolipin antibody assay

Parosysmal nocturnal hemoglobinuria • Primary acquired stem cell disorder, – RBCs or WBCs lacking glycophosphatidalinosital-anchored surface proteins ie CD 55 or CD 59 – Protect cells against compliment mediated destruction • Signs/Symptoms: hemolytic anemia, thromboses at atypical locations, esophageal spasm, erectile dysfunction, pulmonary HTN – Thrombosis is a sign of more aggressive disease • Dx: flow for CD 55/59 • Tx: anticoagulate for thrombosis – ? steroids – eclizumab (anti-C 5) some benefit • Increased risk of meningococcal infection – Immunosupressives +/- HSCT if severe

• 56 M seen in ED for 4 weeks progressive fatigue, DOE, CP with moderate exertion. Unable to work (construction worker) • FH/PMH/Meds: none significant • VS: T 98. 2, BP 123/69 HR 98 RR 16 • Exam: scleral icterus, no adenopathy, +splenomegaly • Hb 8. 1, WBC 4. 9, Plt 159 • Retic 5. 4% • Coombs test: Ig. G strong positive, C 3 weak positive • Smear… • • • Dx? A) Cold agglutinin disease B) G 6 PD deficiency C) hereditary spherocytosis D) TTP E) Warm autoimmune hemolytic anemia


Autoimmune hemolytic anemia • Warm: Ig. G antibodies bind to Rh antigens, ab-coated RBCs removed by spleen. – optimum binding at T 99. 0, • Tx: steroids first-line (2/3 respond) – Splenectomy, rituximab, immunosupressives • Cold: Ig. M antibodies bind to RBC antigens I or i. Abs fix compliment leading to intravascular lysis – Maximal activity at 4 Celsius – Usually a clonal B-cell disorder • Tx: cold avoidance -chlorabmucil or cyclophosphamide, rituximab -plasmapheresis if acute/severe -steroids and splenectomy unhelpful

Autoimmune hemolytic anemia Most common drug in 2012: cephalosporins
- Slides: 38